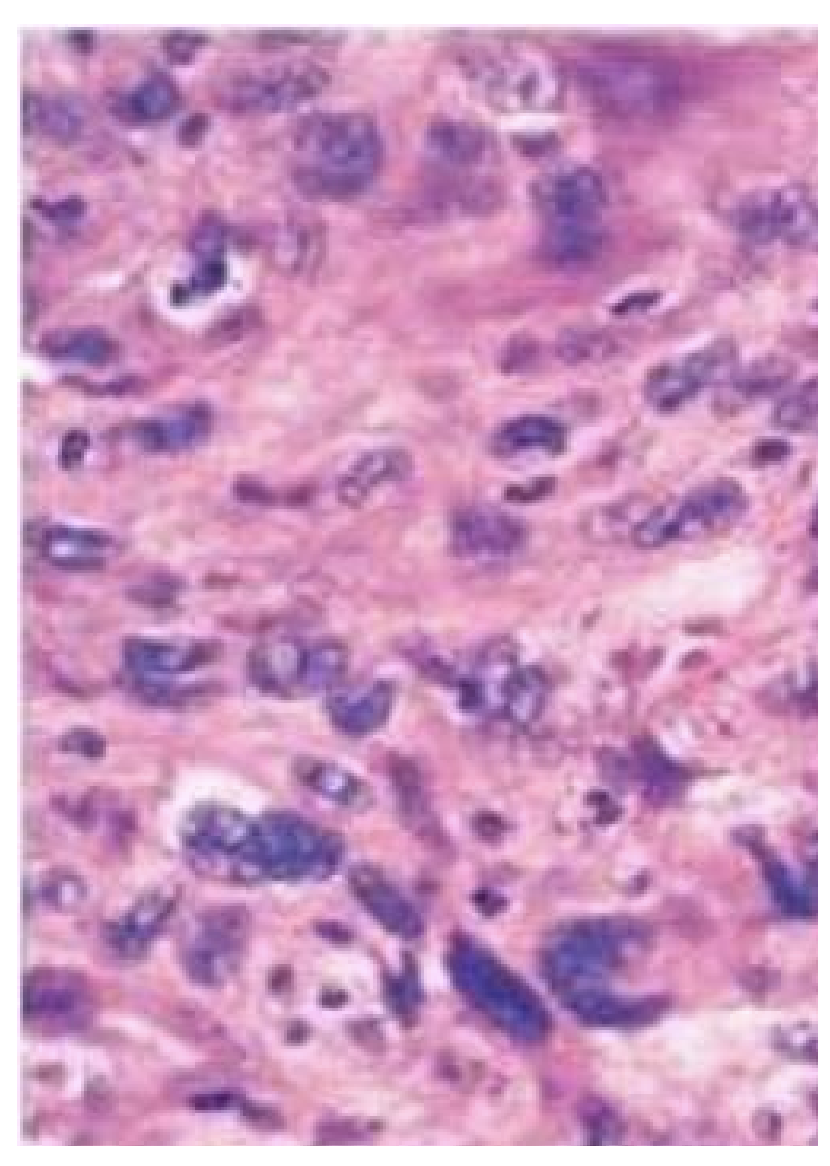

En asiatisk mand på 57 år har symptomer fra maven med dårlig appetit, smerter, kvalme og opkastning. Ved gastroskopi (kikkertundersøgelse af mavesækken) ses ingen overfladeforandringer, men der tages flere, dybe ventrikelbiopsier. Figur A viser del af ventriklens muscularis med grupper af celler, som på figur B er immunfarvede med cytokeratin.
Hvad viser biopsien?
a. hyperplasi af ventriklens kirtler
b. leiomyom i ventrikelvæggen
c. Meckels divertikel
d. slimhindeatrofimedkirtelrester
e. adenokarcinom i ventrikelvæggen

*e. adenokarcinom i ventrikelvæggen
Dette præparat stammer fra en 25 årig mand. Hvilken histologisk diagnose svarer bedst til billedet?
a. Planocellulært karcinom
b. Germinalcelletumor
c. Malignt melanom
d. Lipom

*b. Germinalcelletumor
Hvilken histologisk diagnose svarer bedst til billedet?
a. Lipom
b. Adenokarcinom
c. Teratom
d. Normal mamma

*d. Normal mamma
En bekymret mor henvender sig med sit 2-årige barn, som siden fødslen har haft forandringer på højre side af hovedet, som vist på billedet. Forandringen føles blød. Hvilken diagnose er mest sandsynlig?
a. Lymfangiom
b. Hæmangiom
c. Nævus
d. Malignt melanom

*b. Hæmangiom
Hvilken neoplasi foreligger?
a. Planocellulært karcinom i bronkie
b. Colonadenom
c. Kondylom
d. Blærepapillom

*b. Colonadenom
En 57-årig kvinde, som har røget og drukket siden ungdommen, dør kort efter indlæggelsen med symptomer på hjerneblødning. Ved obduktionen findes lungeforandringer som vist på billedet. Hvilken af nedennævnte diagnoser er mest sandsynlig?
a. Metastaser fra malignt astrocytom
b. Metastaser fra adenokarcinom i pancreas
c. Metastaser fra basocellulært karcinom
d. Metastaser fra malignt melanom

*b. Metastaser fra adenokarcinom i pancreas
Rygning er disponerende faktor for pancreaskræft (25% øget risiko) - sundhed.dk
En 55-årig mand findes død i eget hjem. Ved obduktion ses forandringer i leveren som vist på billedet. Hvilket er følgende af udsagn er korrekt?
a. Der er tale om en atrofisk vækstforstyrrelse.
b. Tilstanden er ikke relateret til alkohol.
c. Makroskopisk beskrives leveren som forstørret og blød.
d. Tilstanden er irreversibel.
e. Mikroskopisk ses fibrøse strøg og regenererende hepatocytter.

*c. Makroskopisk beskrives leveren som forstørret og blød.
En 25-årig mand henvender sig hos egen læge pga. abdominalt ubehag og perioder med diaré. Ved palpation finder egen læge en udfyldning i højre fossa iliaca svarende til ileocøkal-stedet. Lægens tentative diagnose svarer det makroskopiske præparat af tarmen. Hvilket af følgende udsagn er forkert?
a. Makroskopisk vil slimhinden have et brostenslignende relief.
b. Makroskopisk vil tarmvæggen være fortykket.
c. Mikroskopisk ses talrige lymfocytaggregater.
d. Mikroskopisk ses der metaplasi af tarmepitelet
e. Denne patientgruppe har let øget risiko for at udvikle intestinalt karcinom.

*d. Mikroskopisk ses der metaplasi af tarmepitelet
En 66 årig mand falder død om i bussen, og kan ikke genoplives trods sufficient hjertestop behandling på stedet. Ved obduktion gøres fund som vist på foto. Hvilken diagnose kan man stille?
a. Trombe i a. carotis interna
b. Emboli i v. cava inferior
c. Trombe i a. coronaria dextra
d. Emboli i a. pulmonalis
e. Trombe i v. pulmonalis

*d. Emboli i a. pulmonalis
En 71 årig kvinde bliver fundet død i sin seng i hjemmet. Hun var i behandling for diabetes mellitus type 2 og arteriel hypertension. Ved obduktionen gøres fund som vist på foto. Hvorledes vil du benævne hjertets udseende baseret på makroskopisk fund alene?
a. Højresidig ventrikulær hypertrofi
b. Venstresidig ventrikulær hyperplasi
c. Højresidig atriehypertrofi
d. Ventresidig ventrikulær hypertrofi
e. Normal væv

*d. Ventresidig ventrikulær hypertrofi
Venstre ventrikel må max være 15 mm i tykkelse
Ved obduktion findes en forandring i lungevævet, hvor mikroskopi viser følgende (se foto). Hvilken diagnose er der tale om?
a. Planocellulært karcinom
b. Adenokarcinom
c. Nekrotiserende granulomatøs inflammation
d. Akut inflammation
e. Leiomyosarkom

b. Adenokarcinom
Hvilken histologisk diagnose ses på billedet?
a. Planocellulært karcinom
b. Småcellet karcinom
c. Adenokarcinom
d. Leiomyom
e. Teratom

*a. Planocellulært karcinom
Hvilken diagnose svarer bedst til billedet?
a. Kronisk inflammation i hud
b. Planocellulært karcinom i hud
c. Tatoveringspigment i hud
d. Kulstøvsaflejring i hud
e. Malignt melanom i hud

*e. Malignt melanom i hud
Hvilken histologisk diagnose svarer bedst til billedet?
a. Adenokarcinom
b. Planocellulær metaplasi
c. Lipom
d. Leiomyom
e. Normalt bruskvæv

*c. Lipom
Hvilket vækstmønster er som regel malignt?
a. Ekspansiv vækst
b. Papillomatøs vækst
c. Nodulær vækst
d. Diffus vækst
e. Lokal vækst
d. Diffus vækst
Hvilken histologisk diagnose svarer til billedet?
a. Planocellulært karcinom
b. Småcellet lungecancer
c. Adenokarcinom
d. Leiomyom
e. Dermoidcyste

a. Planocellulært karcinom
Hvilken histologisk diagnose svarer bedst til billedet?
a. Småcellet lungecancer
b. Malignt melanom
c. Malignt lymfom
d. Lymfeknude med metastase af adenokarcinom
e. Lymfeknude med metastase af planocellulært karcinom

d. Lymfeknude med metastase af adenokarcinom
Hvilken histologisk diagnose svarer bedst til billedet?
a. Normalt pladeepitel
b. Dysplasi i pladeepitel
c. Planocellulært karcinom
d. Pladeepitelmetaplasi
e. Normalt urotel

b. Dysplasi i pladeepitel
Hvilken histologisk diagnose passer bedst til billedet?
a. Adenom
b. Højt differentieret adenokarcinom
c. Leiomyom
d. Højt differentieret planocellulært karcinom
e. Lavt differentieret karcinom
e. Lavt differentieret karcinom
I bronkieslimhinden findes forandringer som vist på billedet. Hvilken af nedennævnte diagnoser er mest sandsynlig?
a. Småcellet karcinom
b. Pladeepitelmetaplasi
c. Normal bronkievæg
d. Planocellulært karcinom
e. Hyperplastisk epitel

b. Pladeepitelmetaplasi
En 64-årig mand dør med symptomer på stor hjerneblødning. Ved obduktion ses forandringer i leveren som vist på billedet. Hvilken af nedennævnte diagnoser er den sandsynligste?
a. Metastaser fra pancreastumor
b. Levercirrose
c. Benigne levertumorer
d. Metastaser fra hjernetumor
e. Primær levercancer

*a. Metastaser fra pancreastumor
57-årig mand henvist fra e.l. til gastroskopisk udredning grundet længerevarende anamnese med daglige refluxsymptomer (halsbrand, sure opstød og sviende smerter i epigastriet). Ved gastroskopi ses i distale esophagus uregelmæssige røde tunger der strækker sig op i esophagus. Der biopteres herfra og mikroskopisk ses forandringer, som på billedet. Hvilke epitelforandringer ses i biopsien?
a. Metaplastisk cylinderepitel af intestinal type
b. Dysplasi af let grad
c. Alderbetinget atrofi
d. Karcinom
e. Hyperplasi

*a. Metaplastisk cylinderepitel af intestinal type
Det normale pladeepithel i oesophagus er erstattet af cylinderepithel: Barrets oesophagus
Ved obduktion af en 58-årig mand findes forandringer i hjertet som vist på billedet. Hvilken af nedennævnte processer har mest sandsynligt fundet sted i hjertet?
a. Atrofi
b. Metaplasi
c. Neoplasi
d. Hypertrofi
e. Hyperplasi

*d. Hypertrofi
Ikke atrofi: hjertet ser større ud
Ikke hyperplasi: cellerne kan ikke foretage hyperplasi
Det mikroskopiske billede fra colon viser
a. Hyperplastisk polyp
b. Adenom med let dysplasi
c. Adenom med svær dysplasi
d. Colitis ulcerosa
e. Adenokarcinom

*e. Adenokarcinom



























































































